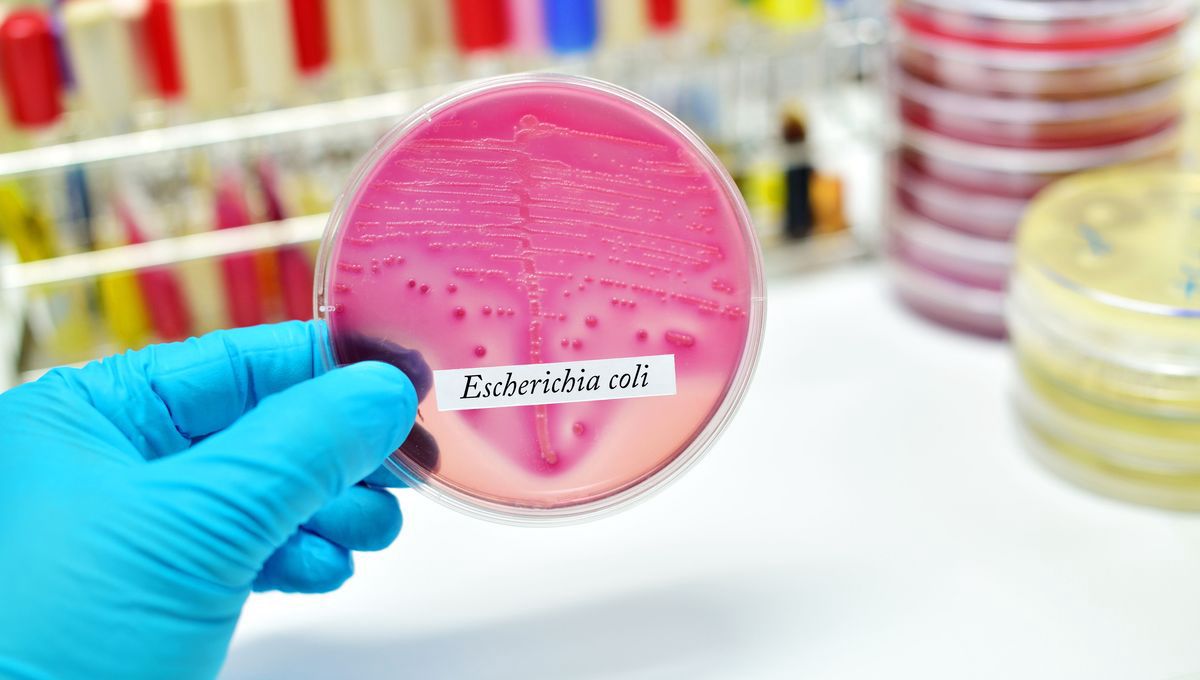

IFLScience
shared a link post in group #IFLScience

www.iflscience.com
Bacteria Gone Bad Could Have A Surprisingly Simple Cause
An enormous portion of global disease could be the result of a strange mutation that keeps reoccurring.

IFLScience

shared a link post in group #IFLScience
www.iflscience.com
Bacteria Gone Bad Could Have A Surprisingly Simple Cause
An enormous portion of global disease could be the result of a strange mutation that keeps reoccurring.
Comment here to discuss with all recipients or tap a user's profile image to discuss privately.
<div data-postid="mzwrqnn" [...] </div>